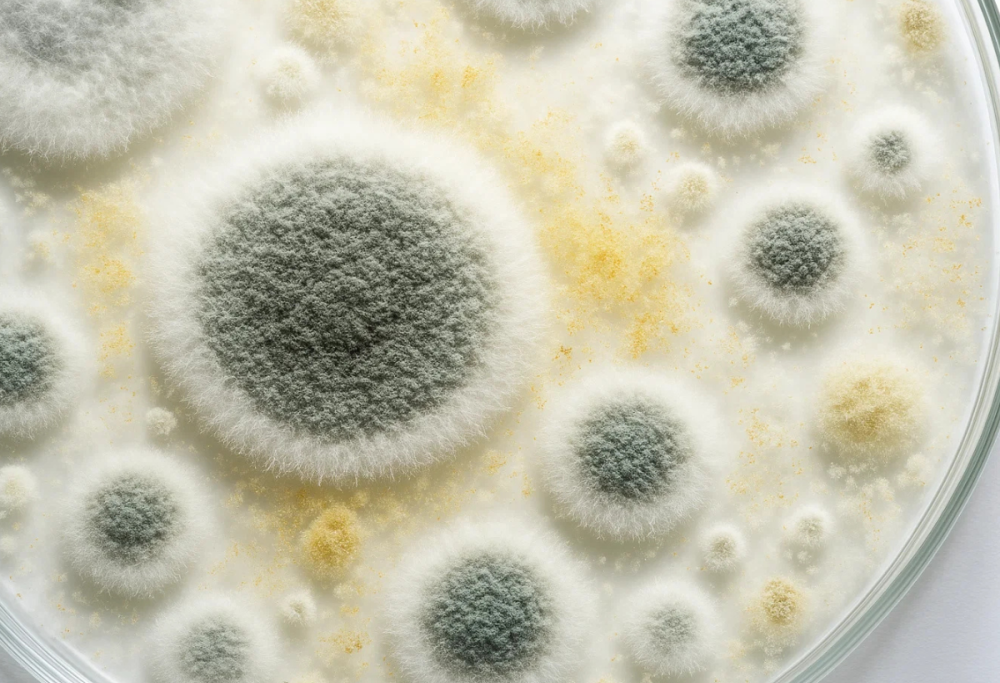

Funghi, muffe e parassiti: i consigli per difendere casa e giardino
Dalla ventilazione ai rimedi naturali, ecco le strategie più efficaci per prevenire infestazioni negli ambienti domestici e nelle piante
2 Settembre 2025
Piccole, quasi invisibili eppure capaci di trasformare i nostri spazi quotidiani in un incubo: muffe, funghi e parassiti sono ospiti indesiderati che si insinuano tra le mura domestiche e nel verde del giardino. Non si tratta solo di un fastidio estetico, ma – come emerge da un’analisi di GreenMe – di una minaccia concreta per la salute e il benessere. Un odore sgradevole che non va via, una macchia che si allarga dietro un mobile o foglie che ingialliscono senza motivo: sono campanelli d’allarme che meritano attenzione immediata.
Prevenzione in casa: aria e umidità sotto controllo
Il primo passo è mantenere l’umidità interna sotto il 60%. Una ventilazione costante, l’uso del deumidificatore e la disposizione corretta dei mobili sono abitudini semplici ma determinanti. Aprire le finestre dopo la doccia o evitare di accostare gli armadi alle pareti esterne aiuta a impedire la formazione di ambienti favorevoli alle muffe.
Difese naturali per piante più resistenti
Anche le piante hanno bisogno di attenzioni mirate. Evitare l’acqua stagnante nei sottovasi e scegliere terricci drenanti riduce il rischio di malattie fungine. Tra i rimedi naturali più efficaci spiccano il bicarbonato di sodio e l’olio di neem, entrambi capaci di creare una barriera protettiva contro i parassiti.
La regola d’oro resta la costanza: monitorare ambienti e piante con regolarità consente di intervenire al primo segnale sospetto, evitando che piccoli problemi si trasformino in infestazioni difficili da gestire.


















